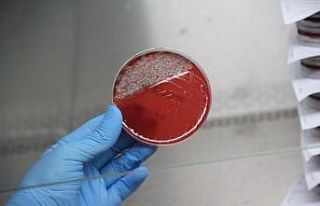
Uzun süre kullanılan maskedeki bakteriler laboratuvarda...

Rize’nin Ardeşen ilçesi eski belediye başkanı Hakan Gültekin, 23 Ekim tarihinde yayınlanan Cumhurbaşkanlığı Kararnamesi ile kısa adı DOKAP olan Doğu Karadeniz Bölgesi Bölge Kalkınma İdaresi Başkanlığı’na atandı.
Cumhurbaşkanı Recep Tayyip Erdoğan’ın imzasıyla yayımlanan kararnamede "Doğu Karadeniz Bölgesi Bölge Kalkınma İdaresi Başkanlığı’na 3 sayılı Cumhurbaşkanlığı Kararnamesi’nin 2. ve 3. maddeleri gereğince Hakan Gültekin atanmıştır" denildi.
Hakan Gültekin kimdir?
Hakan Gültekin, 1970 yılında Rize’nin Ardeşen ilçesinde doğdu. İlkokulu Ardeşen Alparslan İlkokulu’nda, ortaokul ve lise eğitimini Ardeşen İmam Hatip Lisesi’nde tamamladı. 1997 yılında 19 Mayıs Üniversitesi İlahiyat Fakültesinden mezun oldu. Yüksek lisans eğitimini ise Recep Tayyip Erdoğan Üniversitesi Sosyal Bilimler Enstitüsü İşletme Bölümünde tamamladı. 1997 Yılında siyaset ve ticaret hayatına atılan Gültekin, 2002 yılında AK Parti Ardeşen İlçe kurucuları arasında yer aldı. 6,5 yıl AK Parti Ardeşen İlçe Başkanlığı görevini yürüttü. 2009-2012 yılları arasında AK Parti Rize İl Başkanlığı’nda İl Teşkilat ve İl Seçim İşleri Başkanlığı görevinde bulundu. 2014 yılına kadar Rize İl Genel Meclisi Başkanlığı görevinde bulunan Gültekin, 30 Mart 2014 yerel seçimlerinde Ardeşen Belediye başkan adayı oldu ve belediye başkanı seçildi. Gültekin, 31 Mart 2019 yerel seçimlerinde görevi Avni Kahya’ya devretti.